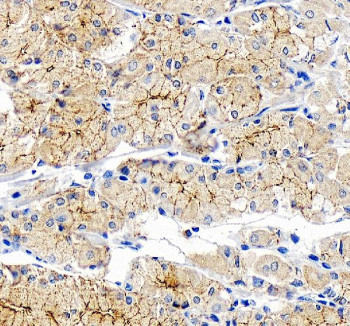
Anti-OCLN / Occludin

Cookie preferences
This website uses cookies, which are necessary for the technical operation of the website and are always set. Other cookies, which increase the comfort when using this website, are used for direct advertising or to facilitate interaction with other websites and social networks, are only set with your consent.
Configuration
Technically required
These cookies are necessary for the basic functions of the shop.
"Allow all cookies" cookie
"Decline all cookies" cookie
CSRF token
Cookie preferences
Currency change
Customer-specific caching
FACT-Finder tracking
Individual prices
Selected shop
Session
Comfort functions
These cookies are used to make the shopping experience even more appealing, for example for the recognition of the visitor.
Note
Show the facebook fanpage in the right blod sidebar
Statistics & Tracking
Affiliate program
Conversion and usertracking via Google Tag Manager
Track device being used
| Item number | Size | Datasheet | Manual | SDS | Delivery time | Quantity | Price |
|---|---|---|---|---|---|---|---|
| NSJ-FY12345 | 100 µg | - | - |
3 - 10 business days* |
790.00€
|
If you have any questions, please use our Contact Form.
You can also order by e-mail: info@biomol.com
Larger quantity required? Request bulk
You can also order by e-mail: info@biomol.com
Larger quantity required? Request bulk
Adding 0.2 ml of distilled water will yield a concentration of 500 ug/ml. The OCLN antibody... more
Product information "Anti-OCLN / Occludin"
Adding 0.2 ml of distilled water will yield a concentration of 500 ug/ml. The OCLN antibody targets Occludin, a key integral membrane protein encoded by the OCLN gene that contributes to tight junction formation and epithelial barrier integrity. Occludin is a 59 kDa tetraspan protein localized at intercellular junctions of epithelial and endothelial cells. It works together with claudins, junctional adhesion molecules (JAMs), and cytoplasmic scaffolding proteins such as ZO-1 to form the tight junction complex that regulates paracellular permeability. The OCLN antibody enables specific detection of Occludin, allowing researchers to investigate the molecular architecture of tight junctions and how their disruption contributes to disease.Occludin plays a central role in maintaining cell polarity, barrier selectivity, and communication between adjacent cells. It acts as both a structural and signaling molecule, participating in pathways that control cell growth and differentiation. Phosphorylation of Occludin on serine, threonine, or tyrosine residues dynamically regulates its interaction with cytoplasmic partners and influences tight junction assembly and disassembly. The OCLN antibody is an essential reagent for tracking these modifications and monitoring Occludin redistribution during epithelial remodeling or inflammation.Mutations in OCLN cause band-like calcification with simplified gyration and polymicrogyria (BLC-PMG), a neurological disorder associated with cortical malformations and hepatic dysfunction. These findings underscore the systemic importance of Occludin beyond epithelial physiology. The OCLN antibody provides researchers with a means to quantify protein levels in both brain and peripheral tissues, aiding studies into developmental and metabolic roles of tight junction components.Occludin dysfunction is also implicated in a range of diseases, including cancer metastasis, viral infection, and inflammatory bowel disease. Pathogens such as hepatitis C virus and cytomegalovirus exploit Occludin to gain cellular entry or modulate junction integrity. Altered Occludin expression can weaken epithelial barriers, promoting invasion or chronic inflammation. The OCLN antibody allows visualization of these alterations in tissue models, helping elucidate how tight junction disruption contributes to pathogenesis.The OCLN antibody performs effectively in immunofluorescence microscopy, immunohistochemistry, and western blotting. In epithelial cultures, staining reveals tight junction localization, while in tissues it highlights barrier organization across endothelium and epithelia. NSJ Bioreagents provides this reagent with validated specificity and reliability for studying Occludin regulation, trafficking, and function. By supporting detailed investigation of tight junction biology, the OCLN antibody helps clarify molecular mechanisms that preserve epithelial homeostasis and their perturbation in human disease.
| Keywords: | Anti-OCLN, Anti-Occludin, OCLN Antibody / Occludin |
| Supplier: | NSJ Bioreagents |
| Supplier-Nr: | FY12345 |
Properties
| Application: | WB, IHC, IP, ELISA |
| Antibody Type: | Polyclonal |
| Conjugate: | No |
| Host: | Rabbit |
| Species reactivity: | human, mouse, rat |
| Immunogen: | E.coli-derived human Occludin/OCLN recombinant protein (Position: S358-Q520) |
| Format: | Purified |
Database Information
| KEGG ID : | K06088 | Matching products |
| UniProt ID : | Q16625 | Matching products |
| Gene ID : | GeneID 100506658 | Matching products |
Handling & Safety
| Storage: | +4°C |
| Shipping: | +4°C (International: +4°C) |
Caution
Our products are for laboratory research use only: Not for administration to humans!
Our products are for laboratory research use only: Not for administration to humans!
Information about the product reference will follow.
more
You will get a certificate here
Viewed